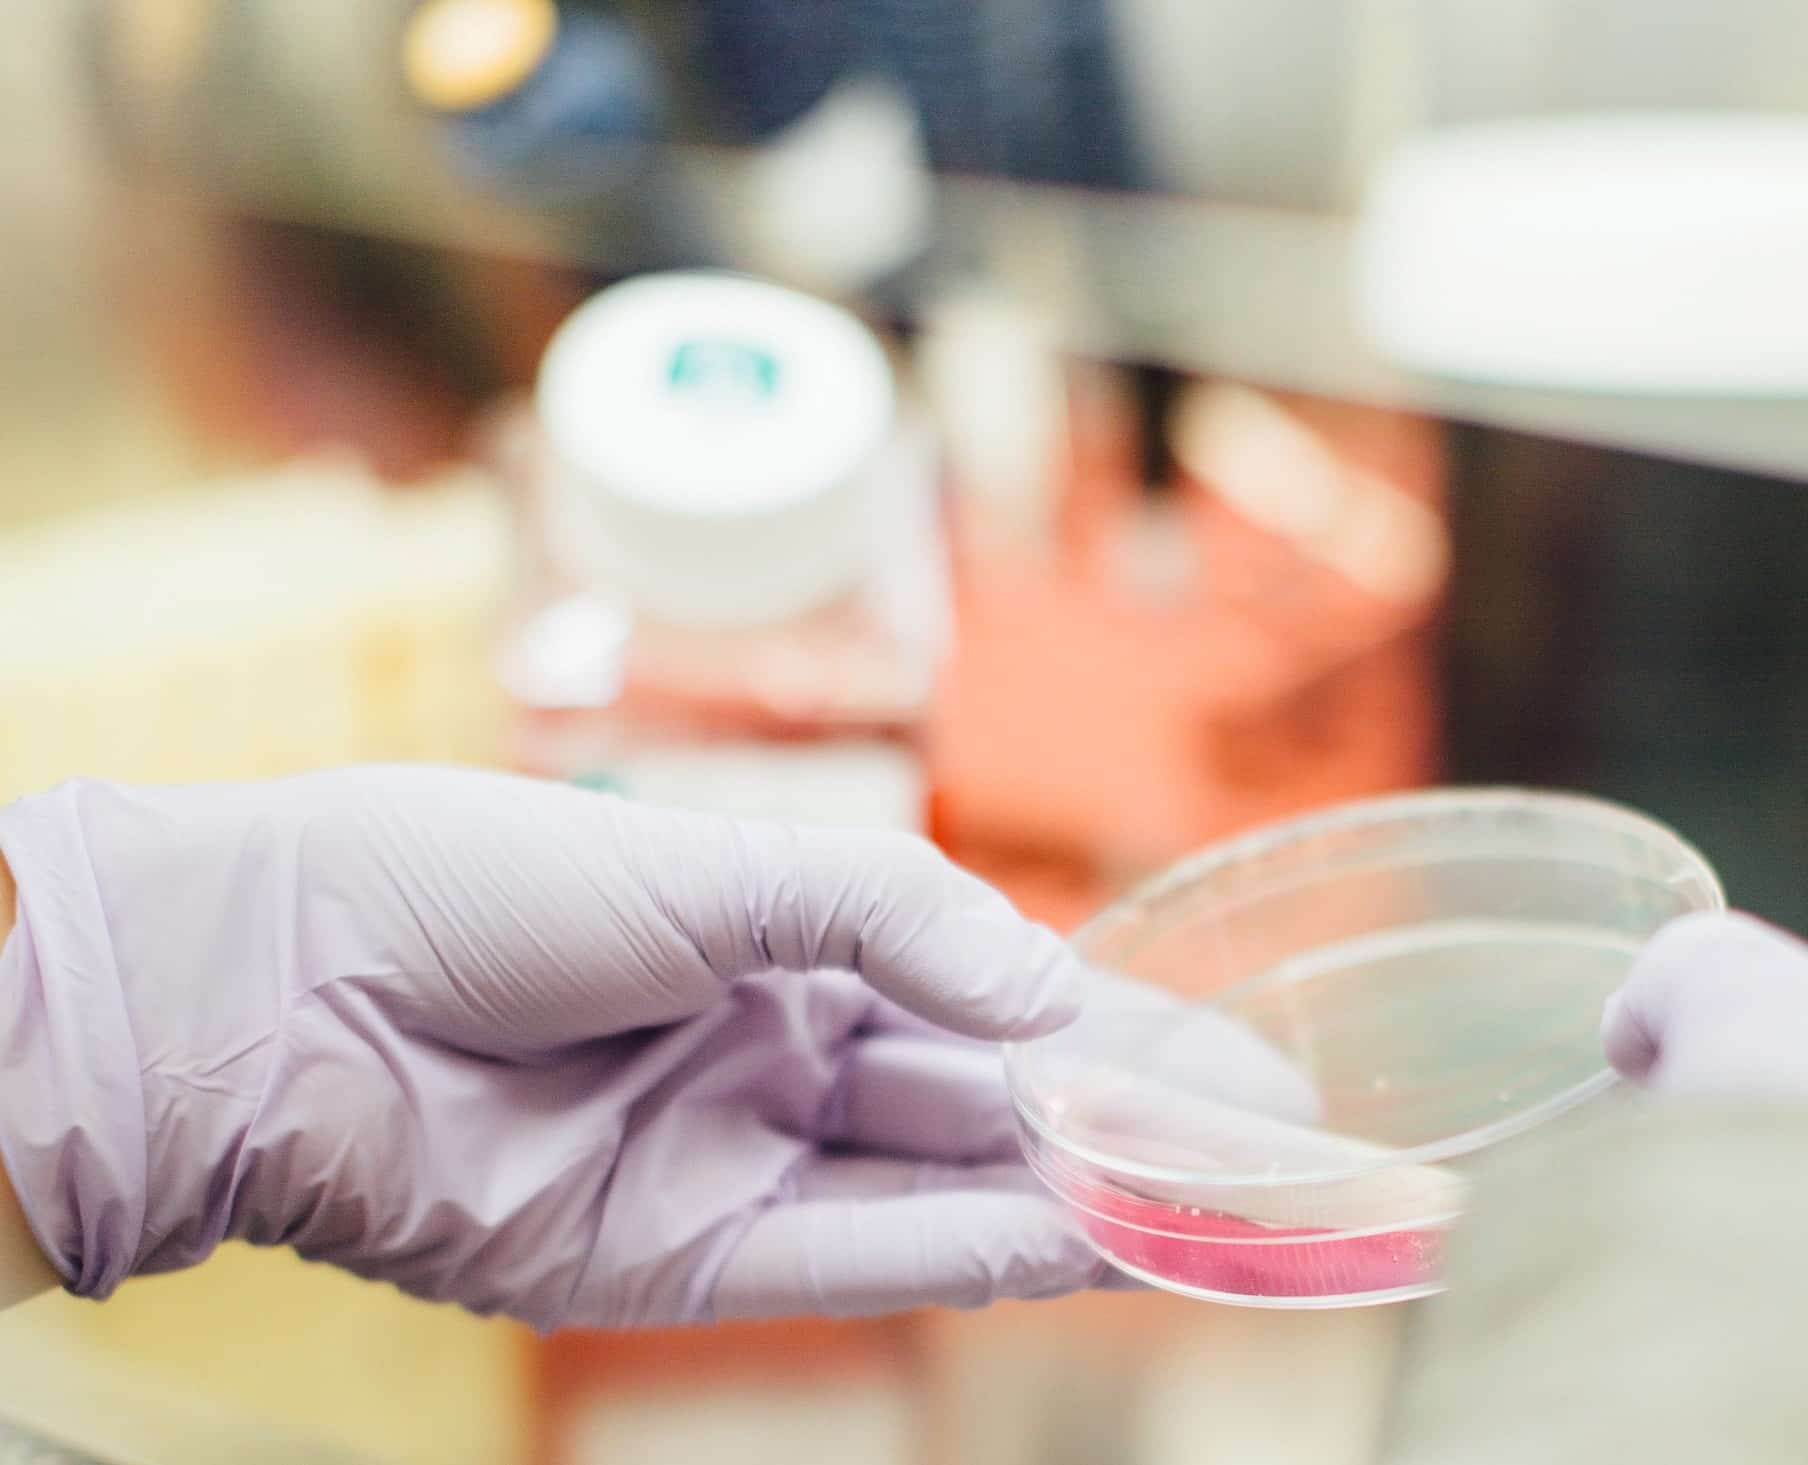
Laboratoire pharmaceutique

Client : Biocodex (France).
Secteur : médical et pharmaceutique.
Besoins : traduction multilingue de contenus scientifiques relatifs à la recherche médicale, destinés notamment à être publiés sur le site du client. Mise en page et édition des contenus traduits.
Volume : contenus variables, allant de 500 mots à 6500 mots.
Solutions : pour ce client, un grand laboratoire pharmaceutique basé en France et présent dans plusieurs pays européens, en Amérique et en Afrique, le chef de projet dédié met en place à chaque projet un processus optimal de traduction incluant une étape d’assurance qualité.
Les textes à traduire comprennent le plus souvent des articles scientifiques (par exemple, sur le microbiote ou encore sur le diabète), des cas cliniques, des témoignages d’experts, des publications médias, des descriptions de vidéos d’information scientifique pour la chaîne YouTube du laboratoire, des quiz, ainsi que des actualités destinées aux professionnels de santé. C’est pourquoi notre agence sélectionne des traducteurs spécialistes du domaine médical et pharmaceutique qui sont chargés de traduire les contenus variés. Il s’agit de traducteurs expérimentés, qui ont l’habitude d’effectuer des traductions pour des laboratoires pharmaceutiques partout dans le monde. En règle générale, les traducteurs ont suivi une double formation en sciences (chimie, biologie, médecine) et en traduction scientifique (telle qu’une formation en traduction destinée à l’industrie pharmaceutique). Des contenus à caractère scientifique strict comme des contenus à visée marketing sont ainsi traduits par notre équipe d’experts. Des éditeurs et graphistes ont finalisé les projets avec une mise en page impeccable, notamment pour les contenus destinés à être envoyés par e-mail ou à être publiés dans des magazines.
Cultures Connection offre un service de traduction de qualité, par conséquent cela fait plusieurs années que ce client fait appel à notre agence.
Découvrez nos services de traduction médicale professionnels !